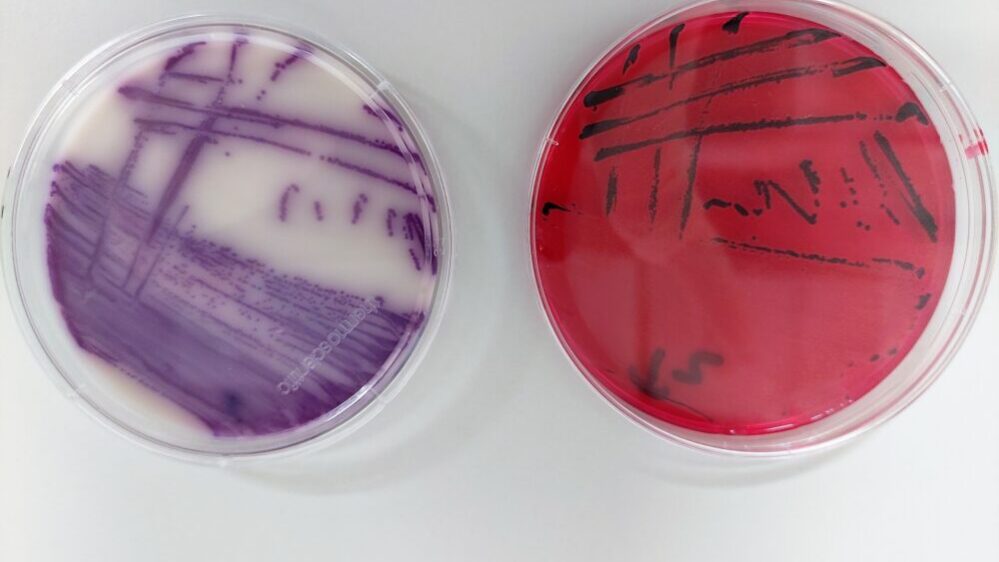

El CITA promueve la creación de la Red Aragonesa Una Sola Salud
El próximo 31 de mayo en el Paraninfo de la Universidad de Zaragoza, el Centro de Investigación y Tecnología Agroalimentaria de Aragón (CITA) y el Instituto Agroalimentario de Aragón (IA2) de la Universidad de Zaragoza organizan la primera jornada de la Red Aragonesa Una Sola Salud (RAUS) que contará con investigadores de reconocido prestigio en el ámbito de la salud animal. El encuentro que tiene como objetivo el establecimiento de un grupo de trabajo aragonés bajo el concepto de Salud Global (una sola salud – One Health) centrado en la prevención de zoonosis y control de antibioresistencias. La jornada será inaugurada por Miguel Gutiérrez, director gerente del CITA, y Rosa Bolea, vicerrectora de Política Científica de la Universidad de Zaragoza a las 9.30 horas.
La jornada contará con tres mesas redondas en las que los expertos se centrarán en temas como la Zoonosis y resistencias antimicrobianas, la Salud Pública y Seguridad Alimentaria y, por último, la Salud Ambiental. Finalizará con las conclusiones de la jornada a cargo de Clara Marín, investigadora del departamento de Ciencia Animal del CITA, e Inmaculada Martín, directora del IA2 de la Universidad de Zaragoza.
Mesas redondas
Moderada por Laura Espina, investigadora ARAID del IA2, la mesa sobre Zoonosis y resistencias antimicrobinanas contará con la participación de Juan José Badiola, catedrático de la Universidad de Zaragoza, Pilar Muñoz, investigadora del Departamento de Ciencia Animal del CITA, y Javier Gómez-Arrue, responsable de Plataforma de Medicina Personalizada de Precisión del Instituto Aragonés de Ciencias de la Salud de Aragón (IACS).
La siguiente mesa se centrará en Salud Pública y Seguridad Alimentaria y será moderada por Agustín Ariño, coordinador del grupo de investigación AESA de la Universidad de Zaragoza, y tendrá como ponentes a Antonio Español, jefe del servicio de Seguridad Alimentaria y Sanidad Ambiental del Servicio de la Dirección General de Salud Pública del Departamento de Sanidad del Gobierno de Aragón, Fernando Laguna, director general de Calidad y Seguridad Alimentaria del Departamento Agricultura, Ganadería y Alimentación del Gobierno de Aragón, y Marta Herrera, profesora e investigadora de la Universidad de Zaragoza.
La última mesa moderada por Irene Pérez Ibarra, investigadora de la Universidad de Zaragoza, tendrá entre sus participantes a Javier Millán, investigador ARAID de la Universidad de Zaragoza, Juan Barriuso, investigador de la Universidad de Zaragoza, y Vicente González investigador del Departamento de Sistemas Forestales, Agrícolas y Medio Ambiente (SAFMA) del CITA.
El encuentro intenta abarcar uno de los objetivos del proyecto Agroalnext “Sistemas de producción ganadera de Aragón y Resistencias Antimicrobianas que afectan a la salud humana (GANARAM)” en el que se fija el establecimiento de una red de trabajo One Health en Aragón centrada en la prevención de zoonosis y control de antibioresistencias.
“Tan poco como sea posible y tanto como sea necesario” es la premisa que, respecto a un uso prudente de tratamientos antibióticos en animales, promueve la Unión Europea mediante el plan de acción “una sola salud” con el que vigila estrechamente las resistencias a los antimicrobianos en el sector veterinario. El objetivo general del proyecto “Sistemas de producción ganadera en Aragón y Resistencias Antimicrobianas que afectan a la salud humana. GANARAM” es realizar una aproximación al papel que puedan desempeñar los diferentes sistemas de producción ganadera de Aragón en la aparición de la resistencia antimicrobiana (RAM) en patógenos que afectan a la salud humana y obtener así información del riesgo de la presencia de RAM en humanos con posible origen en los sistemas de producción de alimentos de origen animal más relevantes de Aragón. El proyecto liderado por Clara Marín forma parte del Plan Complementario Agroalnext dentro del Plan Recuperación, Transformación y Resiliencia financiado por fondos de Unión Europea-Next GenerationEU.